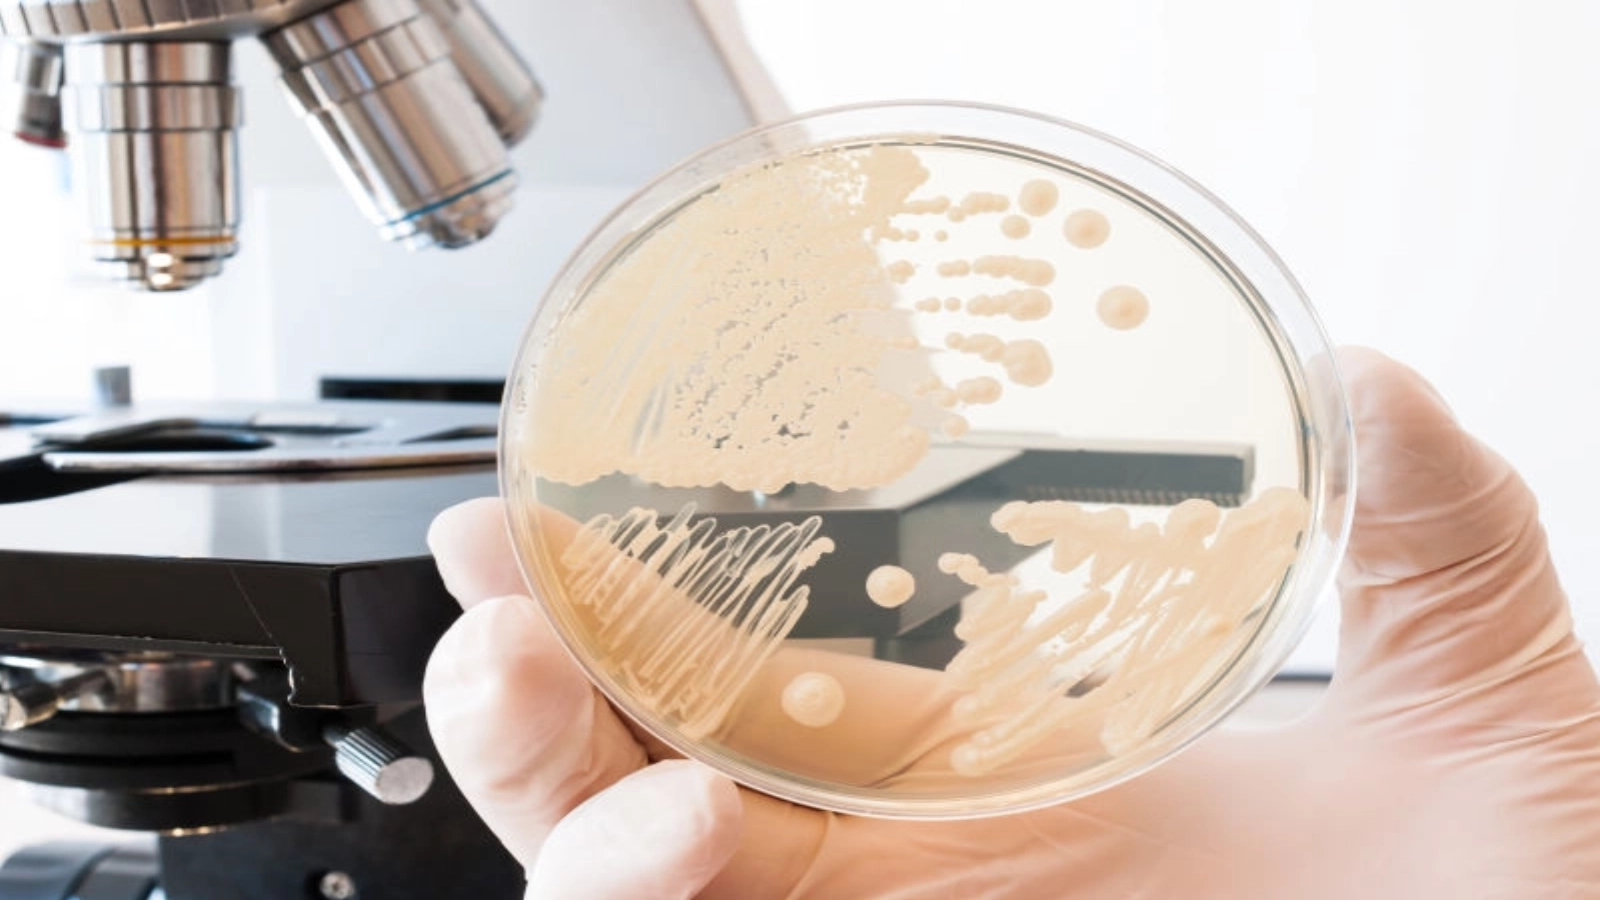
Article thumbnail

O ciupercă rară, cu potențial letal și rezistentă la antibiotice ar putea deveni cel mai nou tip de infecție intraspitalicească ce ar trebui să stârnească îngrijorare, informează New Scientist citând un raport recent al Centrului american pentru controlul bolilor (CDC).
Potrivit raportului publicat la 16 martie, 53 de persoane din Statele Unite s-au îmbolnăvit din cauza Candida auris — majoritatea fiind din statul New York. Alte 27 de persoane sănătoase, dar purtătoare ale ciupercii, au fost identificate în alte trei state în care au fost detectate cazuri clinice, scrie agerpres.ro.
Persoanele cu cel mai mare risc de contaminare cu acest agent patogen fungic rar sunt cele al căror sistem imunitar este slăbit, printre acestea numărându-se în special copiii născuți prematur, diabeticii, pacienții care fac dializă și indivizii care au suferit recent transplanturi sau alte intervenții chirurgicale invazive.
Spre deosebire de infecțiile fungice comune, C. auris este o specie de ciupercă ce pătrunde în sânge și poate cauza întreruperea funcționării anumitor organe și decesul. Rata de mortalitate poate ajunge la 60%, mai indică sursa citată. Totuși, deoarece această ciupercă este contractată de multe ori de la pacient la pacient în unitățile medicale, în timpul perioadei de spitalizare din cauza altor afecțiuni grave, este dificil de demonstrat fără nici o urmă de îndoială ca aceasta este răspunzătoare în mod direct de moartea unor persoane.
Citește și: Femeia acuzată de INCEST spune că va continua relația cu fiul ei, deși judecătorii i-au interzis
Candida auris a fost identificată pentru prima dată în 2009 în Japonia. De atunci, a fost raportată în alte țări precum Canada, Columbia, Germania, India, Israel, Kenya, Kuweit, Norvegia, Pakistan, Spania, Africa de Sud, Coreea de Sud, Marea Britanie și Venezuela. Între mai 2013 și august 2016 au fost raportate primele 13 cazuri în Statele Unite. De atunci, numărul de infecții în această țară a crescut.
Unele tulpini ale ciupercii sunt rezistente la principalele trei clase de medicamente antifungice. ''Este destul de greu de găsit noi antibiotice. E și mai greu de găsit noi antifungice'', a declarat David Denning de la Spitalul Universitar din South Manchester, Marea Britanie'', potrivit sursei citate.
Citește și: INCREDIBIL Faimosul Stephen Hawking pleacă în SPAȚIU
Deoarece oamenii și ciupercile împărtășesc multe dintre căile metabolice comune, o mare parte dintre agenții care distrug ciupercile sunt dăunători pentru utilizarea umană. ''C. auris are potențialul de a fi o problemă foarte dificilă'', a mai spus Denning adăugând însă că majoritatea populației nu are de ce să se îngrijoreze din cauza unei posibile infectări.
Anul trecut, descoperirea acestei superciuperci a condus la închiderea unei unități de terapie intensivă din Londra, mai mulți pacienți fiind infectați cu C. auris, iar unii dintre ei pierzându-și viața în urma cedării mai multor organe, scria în luna iulie The Telegraph.

Comentează